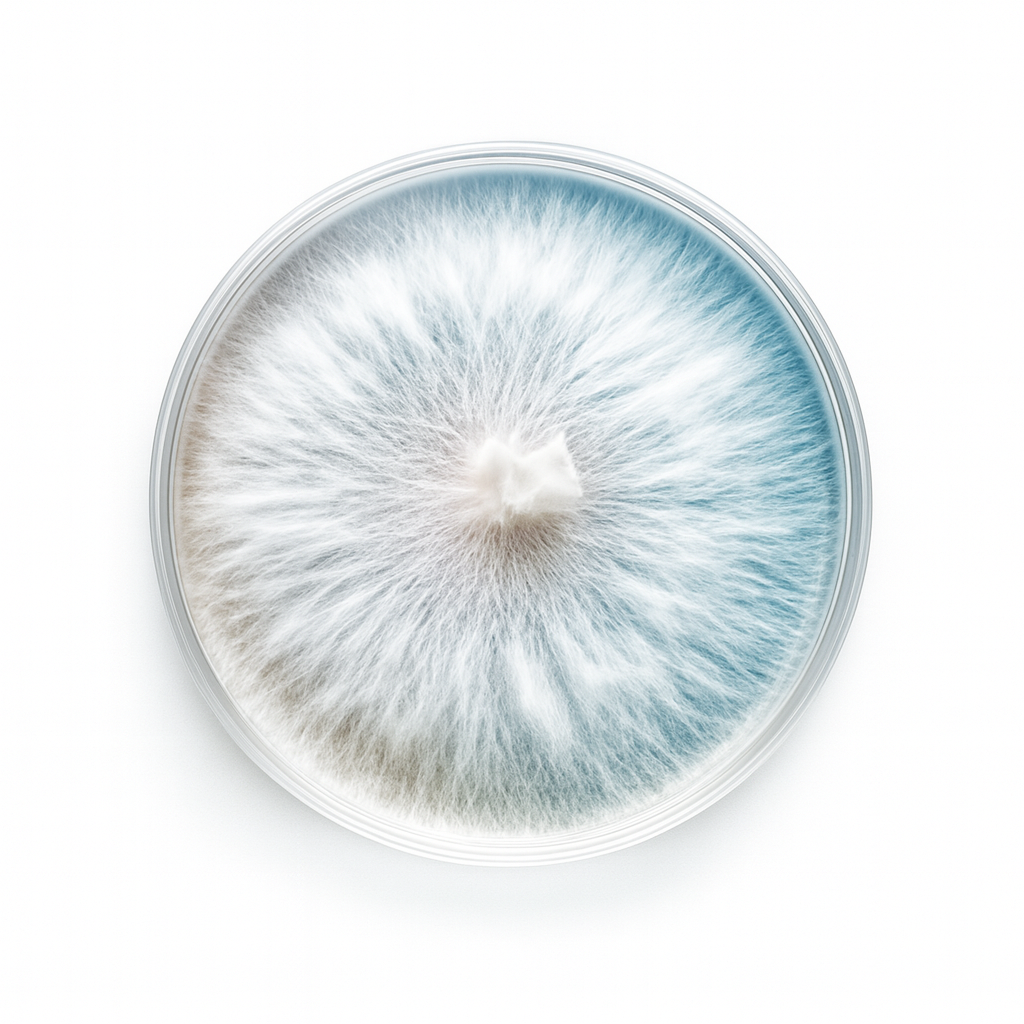

1
/
of
1
90x15 Agar Culture
90x15 Agar Culture
Regular price
$15.00 USD
Regular price
Sale price
$15.00 USD
Quantity
Couldn't load pickup availability
Each sterile Petri dish comes fully colonized with strong, healthy mycelium on nutrient-rich agar. Perfect for expanding cultures, transferring clean mycelium, or starting new grain spawn. These dishes provide a reliable foundation for maintaining genetics and scaling up your mushroom cultivation projects. Ideal for both beginners and experienced growers looking for consistent, contamination-free growth.
Share